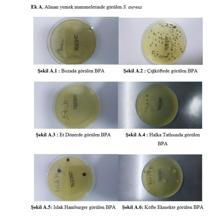
İstanbul'daki araştırmada ürküten sonuç; sokakta satılan ürünler tehlike saçıyor

İstanbul'daki araştırmada ürküten sonuç; sokakta satılan ürünler tehlike saçıyor
İstanbul'da yapılan araştırma sokakta satılan kokoreç, pilav, tavuk döner, boza, soğuk sandviç gibi yiyeceklerin tehlike saçtığını ortaya çıkardı. 1 yıl boyunca yapılan araştırma sonucu alınan numunelerde salmonella gibi tifoya neden olan bakteriler tespit edildi.
Her ülke ve bölgenin yemek kültürünü yansıtan, renkli ve her zaman erişilebilen, maliyeti düşük yemek kültürünün bir parçası olan sokak lezzetleri; hazırlık aşamasının hızlı ve pratik olması gibi birçok sebepten dolayı tercih ediliyor. İstanbul'da yapılan araştırma, sokak lezzetlerinin tüketiminden doğacak mikrobiyolojik riskleri ortaya çıkardı. Test edilen yiyeceklerin yüzde 65'inde "Staphylococcus Aureus", yüzde 25'inde "E.coli", yüzde 10'unda "Salmonella" gibi patojen bakteriler tespit edildi. Boza ve soğuk sandviç gibi ürünlerde tifoya neden salmonellaya rastlanırken, tavuk pilav ve karışık tostta "Staphylococcus Aureus" ve "E.coli" bakterilerinin olduğu ortaya çıktı.
BOZA VE SOĞUK SANDVİÇE DİKKAT!
Araştırma sonuçlarını açıklayan İstanbul Gelişim Üniversitesi'den Dr. Öğretim Üyesi Murat Doğan, "Yüzde 10'luk bir kısımda da Salmonella bulduk. Salmonella da tifoya neden olan bir bakteri. Çok riskli bir bakteri olduğu için bu bulaştığında insanlarda büyük sorunlara neden olabiliyor. Tifo yüzünden geçmişte de milyonlarca insan öldü" dedi.
Numunelerin yüzde 10'luk bölümünde Salmonella bakterisine ulaşıldığına vurgu yapan Doğan, bu bakterinin özellikle boza ve soğuk sandviçte görüldüğü belirtti.
YİYECEKLERİN YÜZDE 65'İNDE GIDA ZEHİRLENMESİ RİSKİ
Doğan, "Sokak yemeklerinin gıda güvenliği açısından değerlendirilmesiyle ilgili Türkiye'de ilk olan bir araştırma yaptık. Yiyeceklerden aldığımız numunelerinin yüzde 65'inde 'Staphylococcus Aureus' çıktı. Bu mikroorganizma özellikle gıda zehirlenmelerine neden oluyor" diye konuştu.
HER 4 YİYECEKTEN 1'İNDE E.COLİ BAKTERİSİ BULUNUYOR
Araştırılan numunelerde her 4 yiyecekten 1'nde 'E.coli' bakterisinin bulunduğunu söyleyen Doğan, "Bu da dışkı kaynaklı, halk sağlığını büyük şekilde tehdit eden bir unsur. Sokak yemeklerinde gıda güvenliği açısından büyük problem yaşanıyor. Bu durum bir an önce kontrol altına alınmalı" ifadelerini kullandı. E.Coli bakterisinin bulunduğu yiyecekler arasında; tavuk döner, tavuklu pilav, Arnavut ciğeri, soğuk sandviç ve karışık tost bulunuyor.
SATICILARIN VE ORTAMLARIN PUANI ÇOK DÜŞÜK
Gelişmiş ülkelerde ve özellikle Japonya'da da sokak yemeklerinin ön planda olduğunu dile getiren İstanbul Gelişim Üniversitesi Güzel Sanatlar Fakültesi Dekan Yardımcısı Dr. Öğretim Üyesi Murat Doğan, "Bunlar hijyenik dizayna göre ve gıda güvenliği açısından standartlara oturtulmuş durumda. Türkiye'de de benzeri çalışmaların yapılması gerekiyor. Resmi olarak sokak yemeklerinin incelenip çözüm bulunması gerekiyor. Bu yiyecekleri hazırlayanların hijyen düzeylerini de ölçtüğümüzde 100 üzerinden 34 puan aldılar. Bu da onların bilgi düzeylerinin yetersiz olduğunu gösteriyor. Ortamlar da gıda güvenliği açısından problemli ve bundan da 100 üzerinden 30 puana ulaşıldı. Satıcılardan alınan el örneklerinden de her 10 kişiden 9'unda problem olduğu görüldü. Sokak lezzetlerini hayatımızdan çıkarmayalım ancak sokak yemeklerinin bir an önce denetim altına alınması ve iyi şekillerde dizayn edilmesi gerekiyor. Sokak lezzetleri gastronominin, yemek kültürünün önemli bir unsuru" dedi.
ELDİVEN TAKMAK ÇÖZÜM DEĞİL
Satıcıların eldiven takmaktan ziyade ellerini sık sık yıkaması gerektiğini dile getiren Doğan, "Eldiven takıp daha sonra o eldivenle hem yiyecekleri hazırlayıp hem de arkasından para verebiliyorlar. Eldiven takması hijyenik olduğu anlamına gelmiyor. Bulunduğu ortamda elini yıkayıp, dezenfekte edebileceği bir ortamın olması gerekiyor. Bu da şu anki koşullarda olmuyor ama bunun bir an önce yapılması gerekiyor" ifadelerini kullandı.
3 AŞAMADAN OLUŞAN ARAŞTIRMA 1 YIL SÜRDÜ
Bir yıl süren araştırmaya imza atanlardan İstanbul Gelişim Üniversitesi Gastronomi Bölümü mezunlarından Berna Aydın ise, “Sokak lezzetleri tarihi bakımından çok eskiye dayanan bir yeme içme kültürü. Sokak lezzetlerinin gıda güvenliği açısından 3 aşamadan oluşan bir araştırma düzenledik. Sokak lezzetlerinde mikrobiyolojik kalitesini ölçme amacıyla laboratuvar ortamında inceledik, ardından sokak satıcılarının gıda güvenliği bilgi düzeylerini ölçmek amacıyla anket yönelttik ve son olarak sokak satıcılarından el swap örnekleri aldık ve inceledik. 1 yıl süren bir çalışma sonrasında bu araştırmayı sunduk. Bu araştırmaya başlamadan önce bu konunun daha önce işlenmediğini ve sokak lezzetleri gibi geleneksel bir yeme içme kültürünün daha kapsamlı araştırılması gerektiğini, gıda güvenliği gibi, insan sağlığı için çok önemli bu konuyu kapsamlı bir şekilde hem insanlara hem de literatüre katkı sağlamak amacıyla yapmak istedik" diye konuştu.
ESNAF KENDİNDEN EMİN
Esnaf ise araştırma sonuçlarının doğru olmadığını söylüyor.
Yaklaşık 15 yıldır döner ustası Bayram Taşkıran, “Etlerimizi en temiz yerlerden alıyoruz. Güzelce terbiyeleyip, dinlendirip, pişiriyoruz. En az 300-350 derecelik bir ateşte pişmesi gerekiyor. Sağlık için el hijyenimize çok dikkat ediyoruz. Maske ve eldiven aynı zamanda depoladığımız yere de dikkat ettiğimiz zaman kesinlikle bir sorun yaşanmıyor" dedi.
Pilavdan tavuk dönere, sosisliden tosta kadar bir çok lezzetin bulunduğu büfenin sahibi Abdülkadir Yılmaz da, “Koronavirüsten önce de hijyenimize dikkat ediyorduk. Hijyene, maskeye, eldivene, titizliğe dikkat ediyoruz. İnsanlar her zaman kaliteyi ve ucuzluğu tercih ediyor" ifadelerini kullandı. Kokoreç satan dükkan sahibi Halil Ece ise, “Tezgahımız açık ve müşterimizin gözünün önünde kurallara uyarak hizmet veriyoruz. Kendimizin yemediği bir şeyi müşteriye de satmıyoruz. Müşteri kazanmak için her zaman iyisini vermemiz lazımö dedi. Kendi yaptığı pilavları satarak para kazanan esnaflardan biri de, “Hijyene koronavirüs başlamadan önce de önem veriyordum. Maskemiz ve eldivenimiz olmadan çalışmaya dikkat ederiz. Her müşteri geldiğinde çamaşır sulu bez ile masaları dezenfekte ediyoruz. Gıda işi hiçbir şeye benzemiyor ve her zaman dikkat istiyor. Gündüz hazırladığım pilavı akşam 5-6'ya kadar tezgahta bulunduruyorum. Kalan olursa ihtiyacı olanlara yoksa da sokak hayvanlarına veriyorum" ifadelerini kullandı.
VATANDAŞ YİYECEĞİ BİLDİĞİ YERDEN ALIYOR
Sokaktaki bazı yiyeceklerin hijyenik olduğuna inanmadığını söyleyen Ali Demir, “Bazıları da evde yapıldığı ve insanların geçimini sağladığı için, ev lezzetini bulmak da mümkün oluyor. Ben evde yapıldığını anlayabiliyorum ve onları tercih ediyorum. Pilav, köfte dışarıda ne satılıyorsa tercih ediyorum" dedi.
Fransa'da yaşayan ve şimdi Türkiye'de olan Nesimi Yılmaz da, “Ben yurt dışındayım ve buraya gelirken bazı lezzetleri tatmayı çok özlüyoruz. Fakat temizliğinden veya yapılırken uygulanan önlemler bizi tereddüte bırakıyor bu yüzden de çekimser kalıyoruz. Kaliteye önem vermek zorundayız. Kalitenin temizliği getirdiğine inanıyorum. Midye ve tükürük köftesi denilen köfte hoşuma gidiyor ama tereddütteyiz yine de yiyoruz" diye konuştu.
Sokak lezzetlerinde genellikle kokoreç ve et döner sevdiğini söyleyen Ebru Yamak, “Tavuk dönerden de uzak dururum çünkü dışardakilerin daha sağlıksız olduğuna inanıyorum" dedi.
Döner tüketmeyi tercih ettiğini söyleyen Sevgi Öner de, “Kokoreç ve midyeden uzak duruyorum. Döneri de her yerden değil güvendiğim yerlerden tercih ediyorum. Zaten son zamanlarda artık onu bile almak istemiyorum" ifadelerini kullandı.